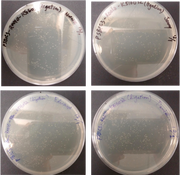

Uploads by Edward Ng
From OpenWetWare
Jump to navigationJump to search
This special page shows all uploaded files.
| Date | Name | Thumbnail | Size | Description |
|---|---|---|---|---|
| 04:21, 16 February 2016 | Expected results of diagnostic restriction generated by Benchling.png (file) |  |
184 KB | |
| 10:34, 2 February 2016 | Plates of pSB1C3-BBa R0010-Bba K516032 candidates colonies after 24 hours incubation.png (file) | |
416 KB | |
| 08:05, 2 February 2016 | Figure 1. Standard assembly of BBa R0010 and BBa K516032.png (file) |  |
65 KB | |
| 07:45, 2 February 2016 | Figure 1. Standard assembly of BBa R0010 and BBa K516032.jpg (file) |  |
38 KB | Figure 1. Standard assembly of BBa_R0010 and BBa_K516032 |
| 17:01, 1 February 2016 | Digested pSB1C3-BBa R0010-BBa K516032 candidates.jpg (file) |  |
188 KB | Digested pSB1C3-BBa_R0010-BBa_K516032 candidates |
| 17:00, 1 February 2016 | Red fluorescence image of pSB1C3-BBa R0010-BBa K516032 candidate colonies.jpg (file) |  |
545 KB | Red fluorescence image of pSB1C3-BBa_R0010-BBa_K516032 candidate colonies |
| 04:01, 8 June 2015 | Table 4 from R&S.PNG (file) |  |
3 KB | |
| 04:00, 8 June 2015 | Table 3 from R&S.PNG (file) |  |
8 KB | |
| 03:59, 8 June 2015 | Table 2 from R&S.PNG (file) |  |
8 KB | |
| 03:57, 8 June 2015 | Table 1 from R&S.PNG (file) |  |
12 KB | |
| 01:29, 8 June 2015 | Plates from R&S.PNG (file) |  |
486 KB | |
| 22:44, 7 June 2015 | Plates.jpg (file) |  |
1.09 MB | |
| 17:55, 7 June 2015 | Colony normal dephosphorylated vector.jpg (file) |  |
169 KB | |
| 16:34, 7 June 2015 | InvestigationReport (1).docx (file) | 1.28 MB | ||
| 17:24, 8 February 2015 | RNA thermometer compiled v2.png (file) |  |
11.26 MB | |
| 17:23, 8 February 2015 | All RNAT.png (file) |  |
272 KB | |
| 17:23, 8 February 2015 | Rna thermometer.png (file) |  |
402 KB | |
| 12:13, 8 February 2015 | Gene.png (file) |  |
332 KB |